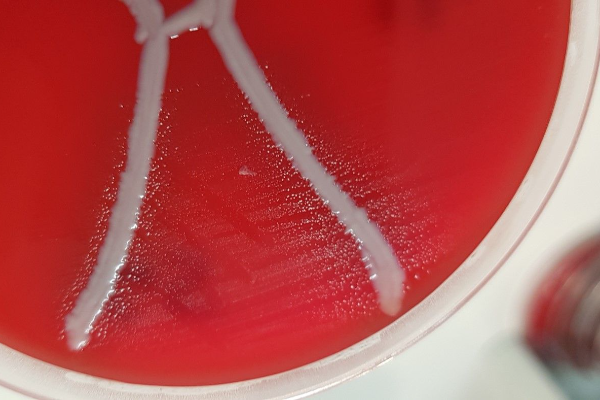

Актинобациллез
Что такое актинобациллез?
Актинобациллез, (Actinobacillosis), проактиномикоз, псевдоактиномикоз - хроническое инфекционное заболевание, протекающее с образованием множественных холодных абсцессов в области головы и шеи, реже - во внутренних органах и полостях (легкие, вымя, полость носа). Заболевание встречается в лесостепной и притаежной зонах, в холмисто-низменных, но не болотистых местах.
Что является возбудителем заболевания?
Возбудитель — Proactinomyces (Actinobacillus) lignieresi (Brumpt), относящийся к актиномицетам. Короткая, грамотрицательная, неподвижная палочка, не образующая спор и капсул. В молодых культурах палочки ветвящиеся, сильно искривлённые; распадаются на кокковидные формы. Возбудители хорошо растут на кровяном и сывороточном агарах, мозговой и синтетических средах. Аэробы, оптимум роста t 37°C, желатин не разжижают. На сывороточном агаре растут в виде бесцветных, гладких, блестящих колоний. В бульоне образуют осадок в виде хлопьев, иногда бульон мутнеет; в тканях и гное — мелкие друзы, состоящие из коккобацилл . К возбудителю восприимчивы самцы морских свинок. Широко распространён в почве, на растениях, его можно обнаружить и на слизистой оболочке ротовой. К актинобациллезу восприимчив крупный и мелкий рогатый скот, свиньи и другие животные. Заболевание зарегистрировано в различных странах Европы, в США. Имели место случаи актинобациллеза и в России.
Как происходит заражение?
Обычно актинобациллез встречается в виде спорадических случаев, но может принимать и характер эпизоотии с летальными исходами у 3-10% заболевших животных.
Заболевают чаще овцы среднего возраста, реже молодняк и старые животные. Болезнь обычно появляется в первые месяцы стойлового содержания. В неблагополучных хозяйствах она достигает максимального развития к марту, охватывая до 60% поголовья. С переводом животных на пастбищное содержание заболевание идет на убыль. Некоторые овцы болеют все лето. Болезнь может рецидивировать и причинять значительный экономический ущерб вследствие падежа, вынужденного убоя, резкого снижения упитанности и продуктивности животных.
Естественное заражение происходит через кожу и слизистые оболочки полости рта, миндалины, травмируемые сухими частями колющих растений. В большинстве случаев поражается лимфатическая система головы и шеи. Иммунитет к актинобациллезу не изучен.
Какие существуют клинические симптомы?
Актинобациллез овец и крупного рогатого скота характеризуется появлением на коже или слизистой оболочке нижней губы холодных одиночных или множественных пустул мутновато-белого цвета. При надавливании они лопаются и из них выделяется густая тягучая белая гноевидная масса без запаха. Затем развивается отек губ, особенно нижней, которая становится каменисто-плотной и выпячивается. По мере развития болезни формируются холодные абсцессы величиной с горошину и с куриное яйцо в межчелюстном пространстве, на боковых поверхностях головы, шеи, в области гортани и околоушной железы, а также в области носа и орбиты глаз. Если отек и абсцессы локализуются в области гортани и носовой полости, то у животных возникает сопящее затрудненное дыхание. Акт также жевания затрудняется. При множественных гнойничковых поражениях голова приобретает обезображенную асимметричную форму. Животные быстро худеют, развивается анемия, нарушается обмен веществ, теряется эластичность кожи, выпадает шерсть на многих участках тела.
У некоторых овец в зоне поражения мягких тканей головы возникают периоститы, сопровождающие деформацией челюстей. При поражении лимфатических сосудов по их ходу образуются соответственно расположенные мелкие абсцессы. В более поздней стадии лимфатические узлы головы, шеи и предлопаточные гнойно расплавляются и самопроизвольно вскрываются. У убитых животных на вскрытии иногда обнаруживают абсцессы во внутренних органах.
У молодняка крупного рогатого скота встречается актинобациллез кожи и подкожной клетчатки, сходный с флегмоной. С развитием процесса мелкие абсцессы в коже и подкожной клетчатке сливаются. Между волокнами мышечной ткани появляется зеленоватый гной с нехорошим запахом.
Нередко заболевание сопровождается поражением молочной железы. Пораженное актинобациллезом вымя становится бугристым. Затем бугорки превращаются в холодные абсцессы. Попавшие в ткани актинобациллы могут вызывать изменения актиномикозного характера (инфекционные гранулемы с друзами).
Описанные симптомы протекают у больных животных, как правило при нормальной температуре. Повышение ее наблюдается в тез случаях, когда актинобациллезный процесс осложняется флегмоной в результате проявления вторичной гноеродной инфекции.
Как диагностировать актинобациллез?
У животных, больных актинобациллезом, отмечается лейкоцитоз со сдвигом ядра влево. Изменение белковых фракций в сторону увеличения бета- и гамма-глобулинов свидетельствует об иммунном ответе организма на внедрение вобудителя. Диагноз ставят на основании клинического осмотра и лабораторных исследований. С этой целью на предметное стекло помещают комочки гноя (друзы) с 15%-ным раствором едкого калия, осторожно раздавливают покровным стеклом и исследуют под микроскопом. В положительных случаях находят лучистые друзы. При необходимости делают посевы растертых кусочков гноя (друз) на скошенный мясо-пептонный агар (МПА) с 20%-ной сывороткой крови овцы или вносят их в мясо-пептонный бульон (МПБ) с тем же количеством сыворотки. Рост актинобацилл подтверждает диагноз.
![]() Существует ли лечение?
Существует ли лечение?
Гнойные очаги после хирургической обработки и промывания от гноя, ветеринар может посоветовать обрабатывать растворами на основе йода и антибиотиков.
Также приносят результат внутривенные инъекции с применением растворов йода.
Каковы меры профилактики?
В неблагополучных хозяйствах по актинобациллезу исключают из рациона грубые корма, собранные с низких, влажных заливных мест, или запаривают их. Нельзя скармливать коровам и овцам сено и силос, содержащие значительные примеси шиповника и других колючих растений. Обеспечивают животных витаминизированными кормами и минеральной подкормкой. Всех больных изолируют и лечат. Неблагополучные стойла, загоны, кошары тщательно очищают от навоза, белят стены, столбы, дезинфицируют кормушки.
Список использованной литературы:
http://zhivotnovodstvo.net.ru/
http://www.cnshb.ru/
https://studme.org/

Written by
Arina TARAN
BreedsMore
IllnessesMore
Forage cropsMore
![]() Патологическая физиология голодания Arina TARAN
Патологическая физиология голодания Arina TARAN![]() Дефицит фосфора (гипофосфатемия) Hipofosfatemi Arina TARAN
Дефицит фосфора (гипофосфатемия) Hipofosfatemi Arina TARAN![]() Какие бывают кормораздатчики для ферм КРС? Irina Makarova
Какие бывают кормораздатчики для ферм КРС? Irina Makarova![]() Кормушки для овец Diana Myakisheva
Кормушки для овец Diana Myakisheva![]() Питание домашних коз: что едят, виды корма и правила кормления Alina Arslantürk
Питание домашних коз: что едят, виды корма и правила кормления Alina Arslantürk![]() Важность минералов питании сельскохозяйственных животных Irina Makarova
Важность минералов питании сельскохозяйственных животных Irina Makarova

 Существует ли лечение?
Существует ли лечение?
















